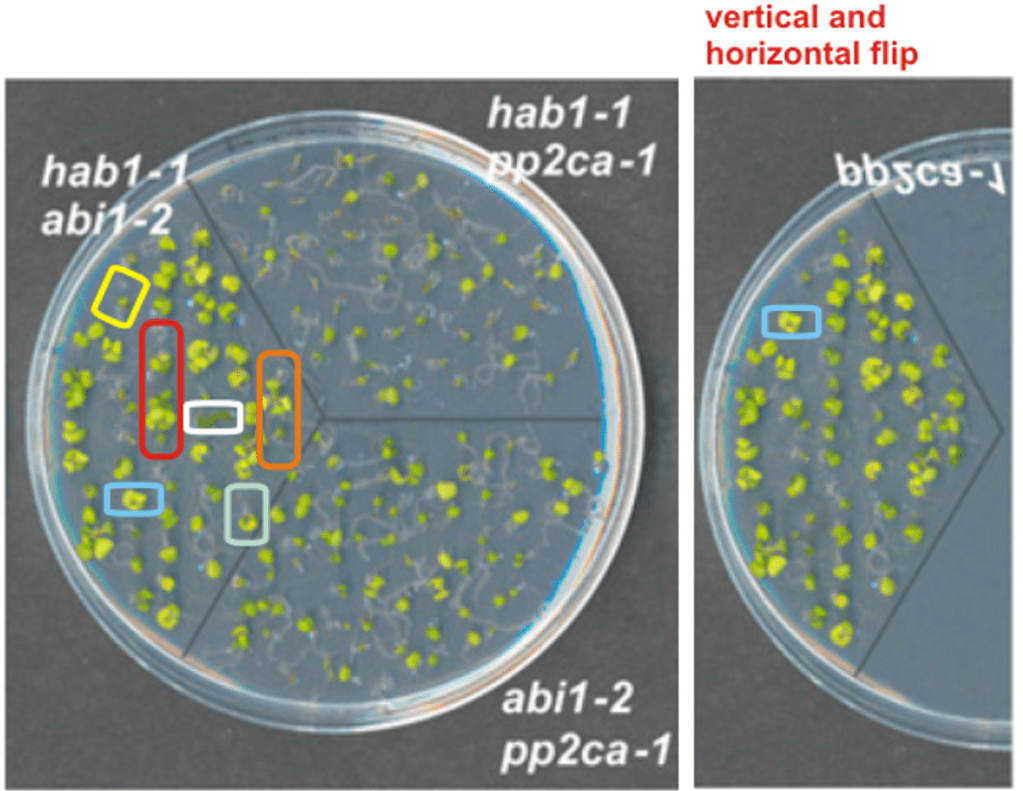

I was wrong and Aneurus Inconstans was right. The field of plant sciences is indeed NOT more honest or more decent than biomedicine. If anything, they are just better in pretending otherwise.
Just look what these society journals proudly corrected, following COPE guidelines of course, and they expect you to be admire them for it even.
Correction: IMPOSSIBLE
By Aneurus Inconstans
We thought plant science had higher standards of integrity and ethics than other research fields. It turned out – it’s exactly same business. A worrisome number of corrections for fake plant papers were accepted by learned society-owned journals in recent months. The number is even larger when considering the last few years. We report here two such corrections that stand out prominently .

In June 2021 the research group of Pedro L. Rodríguez at the Polytechnic University of Valencia (UPV) in Spain, was caught with 17 fake papers published in a time span of fifteen years. If you wish to catch up with Rodríguez & Friends’ story, which is a perfect blend of laughs and tears, I suggest you read the first two chapters of the saga:
Nobody Expects the Spanish Inquisition!
“Recently we realized that some images were used wrongly in the paper, so I want to retract this article. The key message of the paper is very solid and results have been reproduced independently in many laboratories, but I find unacceptable the wrong use of some images during figure preparation” – Pedro L Rodriguez
Científicos al borde de un ataque de nervios
Dead men don’t talk. A dead colleague, especially a foreigner, is a perfect scapegoat to blame for fake data in your papers. And in your own PhD thesis.
We found out that two outrageously fraudulent articles by Rodriguez were corrected some months ago. At the time, we naively believed those two articles had no chance to remain standing. Will we ever learn our lesson?
Correction #1
We start with Santiago et al. 2009, published in The Plant Journal (TPJ), an outlet owned by SEB (Society of Experimental Biology) and published by Wiley. The paper is so fraudulent that even Rodríguez and the first author Julia Santiago, now associate professor at the University of Lausanne in Switzerland, initially agreed to pull it. Instead, it remains standing and is cited 630 times as of today (according to Google Scholar), and got cited about 150 times since the forgeries were discovered in June 2021.
On 24 June 2021, Rodríguez informed the journal with Leonid in cc (highlights mine):
“Dear Editor, we want to make a retraction corresponding to the article: Santiago, J., Rodrigues, A., Saez, A., Rubio, S., Antoni, R., Park, S-Y., Dupeux, F., Marquez, J.A., Cutler, S.R. and Rodriguez, P.L. (2009). Modulation of drought resistance by the abscisic acid-receptor PYL5 through inhibition of clade A PP2Cs. Plant J 60, 575-588. Recently we realized that some images were used wrongly in the paper, so I want to retract this article.The key message of the paper is very solid and results have been reproduced independently in many laboratories, but I find unacceptable the wrong use of some images during figure preparation Please, let me know the procedure. Pedro Rodriguez“
Also Santiago was for a retraction, here her comment in PubPeer (highlights mine):
“I am Julia Santiago the co-first author of this publication […] I contributed to Santiago et al., Plant Journal, 2009: DOI: 10.1111/j.1365-313X.2009.03981.x part of the yeast-two-hybrid (Y2H) experiments now being flagged for image manipulation (Fig. 1). I was not involved in the selection of the figure panels or in the assembly of the final figure for publication. I checked my notes and my contribution to this work further includes the experiments shown in Fig. 3d,e; Fig. 4a,b; Fig. 5; Fig. 6 and the analyses and panels of the ITC binding assays shown in Fig. 7. I did not contribute to the experiments shown in Figures 3b and Figures 4d. I was not involved in the final figure assembly prior to publication. I have left my lab notebooks and all original data generated during my PhD in the host laboratory. Although I have not done any of the flagged image manipulations, I regret that I did not spot these irregularities myself. I fully support retraction of this article and I will do my best to contribute to the clarification of these issues. [Julia Santiago]“
Santiago’s statement is truly peculiar. Despite being co-first author in first position on that paper, apparently she wasn’t involved in any image selection nor figure assembly.
Below are the issues in that paper:
Julia Santiago, Americo Rodrigues, Angela Saez, Silvia Rubio, Regina Antoni, Florine Dupeux, Sang-Youl Park, José Antonio Márquez, Sean R. Cutler, Pedro L. Rodriguez Modulation of drought resistance by the abscisic acid receptor PYL5 through inhibition of clade A PP2Cs The Plant Journal (2009) doi: 10.1111/j.1365-313x.2009.03981.x



In the yeast-two-hybrid (Y2H) assay shown above, twenty-five positive or negative protein-protein interactions are duplicated (boxes of same colour). A few colonies were also digitally modified (red arrows). But the forgeries in Figure 1 weren’t the sole problem.
When Elisabeth Bik with her eagle eyes joined the treasure hunt, it turned out that Figures 3b and 4d were also manipulated. Even copy-pasted seedlings (to the left below), supposed to represent different genotypes, were found:


Because the promised retraction wasn’t coming out, on February 2nd, 2022, I queried the then TPJ Editor-in-Chief Lee Sweetlove about the status of the paper. Two weeks later, on February 18th, 2022, I got an answer from a certain Rosie Trice from the publisher Wiley, whose role and position at Wiley weren’t specified within her signature:
“Thank you for your email that was forwarded to me. Apologies for the time taken to conclude our investigation into this paper. We are actively liaising with the authors and hope to conclude this very soon. Several of the authors are out of contact which can hinder progress. Thank you for your patience. Rosie Trice”

Two and a half years later, when things calmed down, on July 8th, 2024, a correction was issued. I found out about the correction because I queried the journal a couple of weeks ago for an update on the expected retraction. The correction was approved by the new TPJ Editor-in-Chief Katherine Denby, as she informed me (highlights mine):
“Dear all, there has been an investigation into this paper and I was involved in making the final decision on how to proceed (I initially did not recognise the issue). The outcome of this investigation and liaison with authors, was that a correction was published in July 2024. As outlined in the correction, the authors provided original data to correct Figure 1a and b, and provided new experimental evidence (and additional evidence) for Figure 1d and 4d. Figure 3 was simply a correction of a gel splicing error and original images were provided to our integrity team. Following COPE guidelines, and careful checking of the new data and images provided, we decided on a correction rather than retraction of the paper. All the best, Katherine“
Concerns for whites, retractions for the rest?
“Expressions of Concern may be used as an interim notice to flag a potential issue that may be ultimately resolved with another amendment outcome (e.g. retraction or correction) or they may remain as the final outcome in cases where conclusive evidence cannot be obtained. ” – COPE
The correction uses the blatantly false wording “accidental duplications”, and even includes a wrong figure number. It reads the following (highlights mine):
“In the above article, the authors would like to correct and update some of the Figures. Figure 1a and 1b had an accidental duplication and this has been corrected using original data (in Figure 1b the right hand panel of GAD PYL5). Figure 3a [wrong, it is 3b, – A.I.] is correction of a gel splicing presentation error. Accidental duplications of some images in Figures 1d and 4d were removed and experiments repeated (Figure 1d) or additional data included (Figure 4d). The corrected versions of the Figures are presented below.”
The forged Y2H were replaced. Below to the left you can see the new Figure 1, the new data are boxed in green. To the right is the old version:

The Western blots of Fig. 3b were kept identical, but the patch in α-H3 is now gone and the splice is made explicit:

The new Figure 4d (below to the left) includes new data (green boxes), but also holds unexpected surprises:
- One of the duplicated seedlings (magenta boxes), which in the past was describing at the same time the double over-expressor HAB1-OE/PYL5-OE and the over-expressor HAB1-OE, in the new figure describes yet another genotype, the double mutant hab1-1 abi1-2.
- The two seedlings marked with the yellow box in the past were describing the double over-expressor HAB1-OE/PYL5-OE (lines #1 and #2, respectively) treated with ABA. In the new figure they describe PYL5-OE line #2 and the double mutant hab1-1 abi1-2.
- One of the yellow boxed seedlings is mirrored horizontally in respect to the original figure (white asterisk), but not the other. I wonder why.

I find it funny that the authors had to re-use 15 year old images of old seedlings to assemble the new Figure 4d. Did they run out of seeds for re-growing them properly? How in the world could anyone accept to correct this scientific atrocity, when such manipulations in three main figures were caught? And what happened to Rodríguez’ and Santiago’s promise to withdraw the article?
Santiago’s PhD thesis
A little digression. Julia Santiago did her PhD in the laboratory of Pedro Rodríguez in Valencia from 2007 to 2011, but part of the work was performed at the EMBL in Grenoble, France, under the supervision of Jose Antonio Marquez.
Santiago’s PhD thesis includes lots of questionable data. In addition to the issues of Santiago et al. TPJ 2009 described above, blatant manipulations were found in Chapter 4 of her thesis (credits go to anonymous commenter Parus major for digging this out). Those data remain unpublished, for a good reason. Seedlings describing the wild type plants (WT) and the 4a1 mutants are copy-pasted and mirrored horizontally. Additionally, in one case a root was digitally erased, and in another case a leaf was brushed off. There are also forged RT-PCR gels, because why not:


Santiago’s thesis also includes Figures 3A and 4A of Dupeux et al 2011. Both figures are Y2H assays bearing obvious duplications and manipulations:
Florine Dupeux, Regina Antoni, Katja Betz, Julia Santiago, Miguel Gonzalez-Guzman, Lesia Rodriguez, Silvia Rubio, Sang-Youl Park, Sean R. Cutler, Pedro L. Rodriguez, José A. Márquez Modulation of Abscisic Acid Signaling in Vivo by an Engineered Receptor-Insensitive Protein Phosphatase Type 2C Allele PLANT PHYSIOLOGY (2011) doi: 10.1104/pp.110.170894


(by commenter Tristachya superba)

(by commenter Poa sudicola)

After four years, no action has been taken by the American Society of Plant Biologists (ASPB) on Dupeux et al 2011. I complained about it. Apparently a new investigation has been now launched, because everything got lost in 2021. ASPB told me that in 2021 new procedures have been implemented, new editors have taken the place of the old ones, and then floods, earthquakes, locusts…
Iberian yeast masters do it classic with a flip
“These figures were elaborated by me personally and I remember quite well how I made them. Definitely, the images shown in this figure were cut and pasted from the originals in order to elaborate the figures, the overlapping was done “manually” using GIMP…” – Dr. José R Pérez-Castiñeira
Controversies about Santiago’s thesis
- As already mentioned, Dr Santiago claimed she neither assembled any figures nor selected any images for the Santiago et al. TPJ 2009 paper, although she is co-first author in first position.
- Dr Santiago openly accused Dr Americo Rodrigues on PubPeer for producing the Chapter 4 data. She said the data were included in her thesis at the last moment, as requested by her mentor Prof Rodríguez. PubPeer’s moderation removed that comment because against the rules. Later the comment was reposted by Dr Santiago without mentioning the name of Americo Rodrigues as the culprit person.
- Dr Santiago stated she forgot to credit (in her thesis) Dr Americo Rodrigues for Chapter 4 data. Curiously, the Chapter 4 data are not present in Dr Americo Rodrigues’ PhD thesis.
- Sadly, Dr Americo Rodrigues passed away in 2020 and cannot reply to those allegations.
- Dr Santiago denied she produced the data of figures 3A and 4A from Dupeux et al 2011, although the data are presented as hers in her own thesis, no credit to anyone else is reported. Americo Rodrigues was not included in the Dupeux et al 2011 paper, nor were these figures included in his own PhD thesis.
- Figures 3A and 4A of Dupeux et al 2011 are additionally included in Dr Regina Antoni’s thesis. Dr Antoni’s thesis was submitted two years after Dr Santiago’s.

Correction #2
Below is another correction to one of the eleven Rodriguez’ papers with manipulations. This time Julia Santiago is a middle author. The journal is Plant Physiology, owned by the American Society of Plant Biologists (ASPB). This journal is nowadays (but not at that time) published by Oxford University Press (OUP).
Silvia Rubio, Americo Rodrigues, Angela Saez, Marie B. Dizon, Alexander Galle, Tae-Houn Kim, Julia Santiago, Jaume Flexas, Julian I. Schroeder, Pedro L. Rodriguez Triple Loss of Function of Protein Phosphatases Type 2C Leads to Partial Constitutive Response to Endogenous Abscisic Acid PLANT PHYSIOLOGY (2009) doi: 10.1104/pp.109.137174

Again it was Elisabeth Bik who found out that in Figure 4C seedlings grown on MS plates containing 200 nM ABA, supposed to represent the double mutant hab1-1 abi1-2 and the mutant pp2ca-1 respectively, were actually sharing a common origin. The little plants are mirrored horizontally, rotated by 180 degrees, and about half of them were digitally modified:

Elisabeth Bik’s renowned game “Spot The Issues” on Twitter (now X) triggered the interest of many followers. One of them, Karen Maxwell, spotted additional duplications within plate pp2ca-1 (to the right, black circles).
One may wonder what was the reason for cheating so badly on these data. Probably the real germination rates of those mutants weren’t like the authors favoured. As Figure 4C was heavily manipulated, a correction appeared to be out of discussion, no? Forget about it.
On March 29th, 2024, the paper got corrected. The correction note uses the term “duplication”, instead of “manipulation”, excerpts:
“In the originally published version of this manuscript, duplication was present in Figure 4C […]
Figure 4C was generated in the last author’s laboratory. Authors apologize that this problem was not detected during the preparation of the manuscript.
[…]The new mutants described in this article in 2009, particularly the triple pp2c mutants, have been widely used by the ABA research community and their phenotype has been reproduced in different laboratories.
Additionally, new repeat experiments described below indicate that the main findings of the work (physiological characterization of double and triple pp2c mutants) are reliable.
Given that the pp2ca-1 image affects germination data of figure 4B for the pp2ca mutant, the authors repeated this set of experiments.”
The correction provides new germination rate measurements:
As always, we ask ourselves the fateful question: can a student who is caught cheating badly be allowed to retake the exam and then pass?
In 2021, when I reported the paper to ASPB, the Editor-in-Chief was Mike Blatt, who used to demand from anonymous whistleblowers to know their real identity as a prerequisite to proceed, regardless how serious the reported irregularities were. I accepted to play along Blatt’s silly rules and revealed my identity. It wasn’t enough for Iron Mike. He further asked for my affiliation and expertise. Since January 1st, 2022, the Editor-in-Chief is Yunde Zhao, who obviously found authors’ suggested correction irresistible.
Blatt is back: “open debate cornerstone of scientific process”
Michael Blatt, Regius Professor of Botany at the University of Glasgow and Editor-in-Chief of the journal Plant Physiology, is back into the arena, fighting against the anonymity in post-publication peer review (PPPR). I have been in regular email exchange with Blatt, as indicated in my earlier blog post about the advantages of signed PPPR. Now…
At the time we had diligently informed all the stakeholders involved. Not only the journals, also the universities of Valencia and Lausanne and even the European Research Council (ERC) were alerted, for Santiago was running her own lab in Lausanne through a generous ERC grant of €1.5 million. Naturally, we received reassuring responses from everyone saying that everything would be done to clarify the situation through a rigorous investigation carried out along well established and transparent protocols.
COPE rules
Another questionable correction was accepted by ASPB for Irigoyen et al. 2014, a paper from Vicente Rubio‘s lab published in The Plant Cell, where Pedro Rodríguez is a middle author. As a side note, Vicente Rubio has his own PubPeer record.
María Luisa Irigoyen, Elisa Iniesto, Lesia Rodriguez , María Isabel Puga, Yuki Yanagawa , Elah Pick, Elizabeth Strickland , Javier Paz-Ares, Ning Wei , Geert De Jaeger, Pedro L. Rodriguez, Xing Wang Deng , Vicente Rubio Targeted degradation of abscisic acid receptors is mediated by the ubiquitin ligase substrate adaptor DDA1 in Arabidopsis The Plant Cell (2014) doi: 10.1105/tpc.113.122234

Figure 5G and 6B

ASPB’s Vice President and Content & Communications manager Dr Sarah Black kindly shared a workflow written by the Committee on Publication Ethics (COPE) and Springer Nature that outlines the steps that publishers must undertake to adhere to an ethical and thorough investigation.

According to the flowchart, right at the beginning (highlighted in green), the very first step is to ask:
- is it obvious that part/s of an image have been selectively edited affecting conclusions?
- if Yes –> CONSIDER RETRACTION
End of story, according to this workflow, they had to retract.
Lower in the flowchart it is stated that, when the manipulation isn’t obvious at first but then authors admit there’s one (highlighted in red), the first option is:
- PUBLISH A RETRACTION
Astonishingly though, when authors themselves admit manipulation, a second option exists:
- OR CONSIDER A CORRECTION IF THE MANIPULATION IS VERY MINOR AND THE MAJORITY OF THE RESULTS AND CONCLUSIONS OF THE ARTICLE REMAIN VALID
How absurd is that, dear readers? Can manipulations in Rubio et al. 2009 be considered very minor? And what is the threshold to distinguish between minor and major? What does “the majority of the results and conclusions” mean? For instance, if a paper concludes five things, is faking two of them not enough to retract?
In July 2022, the paper by Rubio and Rodriguez was corrected:
“To dispel any doubt, the co-immunoprecipitation assays were repeated and a corrected version of Figure 6B was prepared. Figure 5G stays the same as it is correct. […]
To eliminate any concerns, both assays were repeated and corrected versions of Figures 6C and 6D were prepared. […] These corrections do not alter any of the findings or conclusions presented in the manuscript. We apologize for any inconvenience caused by these mistakes.”
We’ve pointed out to ASPB that their investigation did not follow the COPE rules. But then again, Santiago must have many friends among ASPB members, since she received the ASPB’s Early Career Award in 2017.

Pedro of Arabia
On the other hand, our indefatigable Pedro Rodríguez is not interested in money. He works hard by vocation. Here are his words to Leonid in a heartfelt email, where Pedro tried to explain himself and his relationship with science:
“My salary (32 years in science) is now 2-fold a postdoc salary (surprised? far from European standards?). Well, this is Spain, where Science is not a top job, mostly vocational.”
[Pedro Rodríguez]
Right, vocational. Which doesn’t quite fit with what El Pais reported in July 2023, when the newspaper found out that Rodriguez was among those Spaniards who had a well-paid second job in Saudi Arabia. The Saudi plot was simple: bribe European scientists to add fictional affiliations of Saudi universities to their publications, so that Saudis can cheat in the ranking of the best universities in the world (also read Shorts 07.07.2023).
The El Pais article focussed on the papermiller Damià Barceló, but not only (Google-translated):
“In addition to the chemist Damià Barceló, four other CSIC scientists have declared that they work in Saudi Arabia: the microbiologist Francisco Tomás Barberán , former director of the Segura Center for Pedology and Applied Biology, in Murcia; physicist Andrés Castellanos , from the Institute of Materials Science, in Madrid, and recent winner of the National Research Award for Young People; the biologist Pedro Rodríguez Egea , from the Institute of Plant Molecular and Cellular Biology, in Valencia; also a biologist Roberto Fernández Lafuente , from the Institute of Catalysis and Petrochemistry, in Madrid.”
Cunning Julia, too shrewd to fall
It was really clever by the cunning and talented Julia to put all the blame on poor deceased Americo Rodrigues for the incredible manipulations in her own doctoral thesis and the resulting articles. Two retractions would have had a nasty impact to the trajectory of the rising star Santiago, who was awarded a prestigious ERC Starting Grant of €1.5 million in 2017 to start her own lab.
Many more millions were up for grabs, though. Retractions had to be halted at any cost by Julia and UNIL. In fact, in 2023 the Swiss National Science Foundation (SNSF) awarded Dr Santiago a Consolidator Grant for a period of five years, with a total amount exceeding CHF 4.2 million ($4.7M). Current ongoing projects in Santiago’s capacity amount to CHF 4.9 million ($5.6M). Not too bad for someone with photoshopped data in her PhD papers, because in order to pursue your dream career in science, dedication is key.
It would all be laughable if it weren’t for the tears.
Addendum by LS:
Julia Santiago Cuellar owes her success and untouchability not only to her creative skills, but also to the unwavering support from some very powerful peers in Switzerland. One is her former mentor Michael Hothorn, professor at the University of Geneva. Another is Cyril Zipfel, who co-chairs with Santiago a recently awarded SNSF grant of CHF 1.4 million. Zipfel is since 2018 professor of University of Zürich in Switzerland, and prior to that he was Head of The Sainsbury Laboratory (TSL) in Norwich, UK. In that TSL job, Zipfel was the central figure in charge of investigating the Olivier Voinnet fraud affair. Voinnet did his PhD at TSL, thus not only his peer-reviewed papers but also his PhD thesis were investigated.
Olivier Voinnet, the new Dreyfus?
Much of French media and academia, and certainly also the international plant science community now debates a hot conspiracy theory: what if Olivier Voinnet is actually innocent, a visionary genius who fell prey to a conspiracy of fraudulent colleagues and scheming bureaucrats? I discuss here the widespread dishonesty and data manipulation among Voinnet’s co-authors and…
In the wake of the Voinnet affair, Zipfel published this correspondence piece, in Nature:
Sophien Kamoun & Cyril Zipfel Scientific record: Class uncorrected errors as misconduct Nature (2016) DOI: 10.1038/531173e
“We propose that failure by authors to correct their mistakes should be classified as scientific misconduct. […] The responsibility to correct errors lies mainly with the criticized authors. Snubbing criticism by not addressing it promptly runs counter to our fundamental ethos as scientists, and threatens to erode society’s trust in the scientific community.”
Do those forgeries and the corrections erode society’s trust, maybe? On 11 March 2025, I contacted Zipfel regarding his collaboration with Santiago. This was his angry reply:
“I cannot comment on the alleged issues with the many publications by Pedro Rodriguez (with or without Julia Santiago as author), which is an official matter for institutional and publishing commissions.
I have however followed with great details the work of Julia Santiago as a postdoc in the group of Michael Hothorn and then in her own lab, and have indeed collaborated with her in multiple projects in recent years (https://pubmed.ncbi.nlm.nih.gov/?term=zipfel+C+santiago+J&sort=date; https://data.snf.ch/grants/grant/10001549). These experiences have reassured me about her impeccable rigor and high scientific standards.”
By the way, in 2018 Olivier Voinnet was completely whitewashed by the University of East Anglia, to which Zipfel and his TSL outsourced their investigation. The cheater remains professor at ETH Zürich, thus Zipfel’s neighbour. In 2020, Voinnet was rewarded with an SNSF grant.
Olivier Voinnet: not guilty in past, present and future
Olivier Voinnet, responsible for probably the biggest fraud scandal in plant sciences, is back in the news. His present employer ETH Zürich has now concluded, in collaboration with CNRS, their second investigation into data manipulations in Voinnet papers. The ETH professor was declared innocent of any data manipulations, in the past, present and even future.…
If what Santiago published is “impeccable rigor and high scientific standards” according to highest self-appointed ethics authority in plant sciences, maybe science is supposed to be fake?

Donate!
If you are interested to support my work, you can leave here a small tip of $5. Or several of small tips, just increase the amount as you like (2x=€10; 5x=€25). Your generous patronage of my journalism will be most appreciated!
€5.00

I must commend the authors for the excellent work. For some reason I can’t quite ascertain, I find this whole matter rather more heartbreaking than usual. Very clearly this young woman has been guilty of research misconduct throughout her entire career. I hope that justice is brought to bear on her funding, her professorship, and ultimately on her ill-gotten degree.
LikeLiked by 1 person
https://pubpeer.com/publications/89096FB56EFA4D7511376DED0583F3
https://pubpeer.com/publications/66E7F9A5F017BE52F53A2CE7FAADB6
https://pubpeer.com/publications/769C1D00434608E7BB667466F7E09E
https://pubpeer.com/publications/55492D62595D926BDF0388F85E4BD2
https://pubpeer.com/publications/9DF0AD8F52B9D503AC9891292AD5BA
https://pubpeer.com/publications/4B8AB40750DF03B9FE8A550390A8E4
https://pubpeer.com/publications/9A9F71CE8F4C285674C7D47000EB64
LikeLiked by 1 person
PubPeer – Involvement of Arabidopsis Hexokinase1 in Cell Death Mediate…
LikeLiked by 2 people
I find it fascinating that such fraudulent publications may have contributed to securing high-level positions or substantial funding for their authors. Marion Clavel, a former PhD student of Jean-Marc Deragon and postdoc of Pascal Genschik, is now a junior group leader at MPI Golm, and it appears that Moussa Benhamed even reached the ERC. Two perfect examples of the lack of oversight in the current scientific system and the unacceptable shortcuts some individuals are granted. It is worth noting that Cécile Raynaud is a member of the French national committee and takes part in deciding the future of young researchers aspiring to join the CNRS—many of whom are surely far more ethical than she is. Hopefully, the members of this team will never be part of it again “for better science”…
LikeLike
https://pubpeer.com/publications/F1CD48D9B34142380E5B05D712D416
https://pubpeer.com/publications/1B010904DB4E257E1FC1B1DC937B27
https://pubpeer.com/publications/BC25EBB0A8A2A8AB83BA4D868353D7
LikeLike
Let’s hope this story widely circulates in Lausanne. This is truly a scandal.
LikeLiked by 1 person
As is common for such fields, in plant sciences there is also a thick layer of papermill benthos. Just take another stupid nano-, pardon, porno-formulation, pour it onto your seedlings and watch them grow like crazy in the most unfavorable conditions.
Roohallah Saberi-Riseh is a good example of that, and so are most of the 100+ papers bulk-retracted from PLoS ONE in late 2022, like this one.
LikeLiked by 1 person
The first blow was struck to this house of cards set up by Rodriguez and Santiago.
In August 2025, six Expression of Concern have been issued by ASPB and Oxford Uni Press to papers by Roddy and the cunning Julia:
https://pubpeer.com/publications/2822F2E009564E259F7DCC51FF61B3
https://pubpeer.com/publications/2AC436202486063EE3BB083B68689F
https://pubpeer.com/publications/98D9A98C1C40842ACD60485ACBB5AC
https://pubpeer.com/publications/70C7EEF4DCAF6EC30CDA96056C4E4B
https://pubpeer.com/publications/0E1F7AC125E93D983A952B1D342F20
https://pubpeer.com/publications/F68F6869A1FEAA0CC99235A3F01286
Those EoCs are temporary, as the final outcome is still pending. Unfortunately, there’s still to wait until well deserved retractions will be issued to these “researchers”.
LikeLike